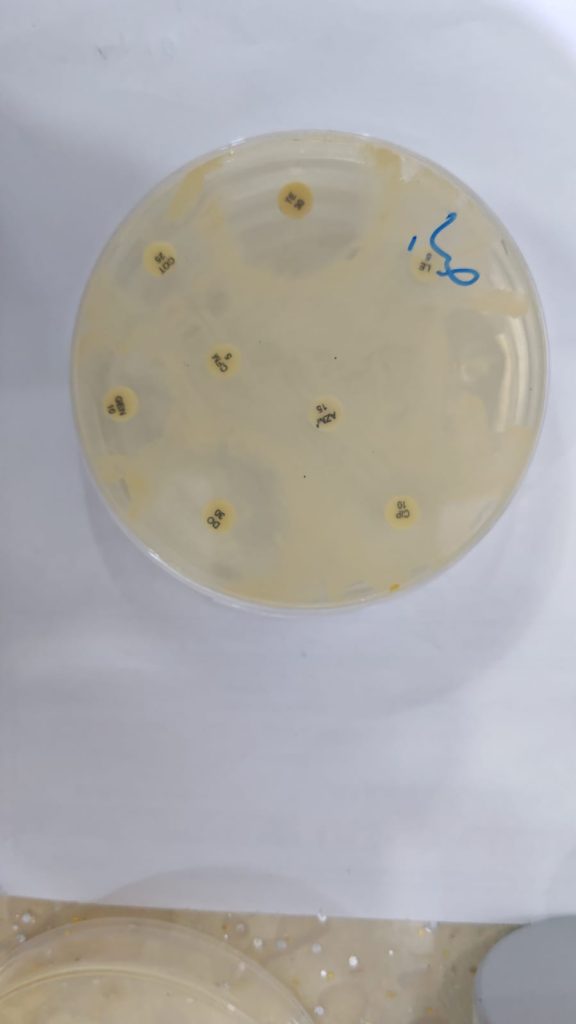
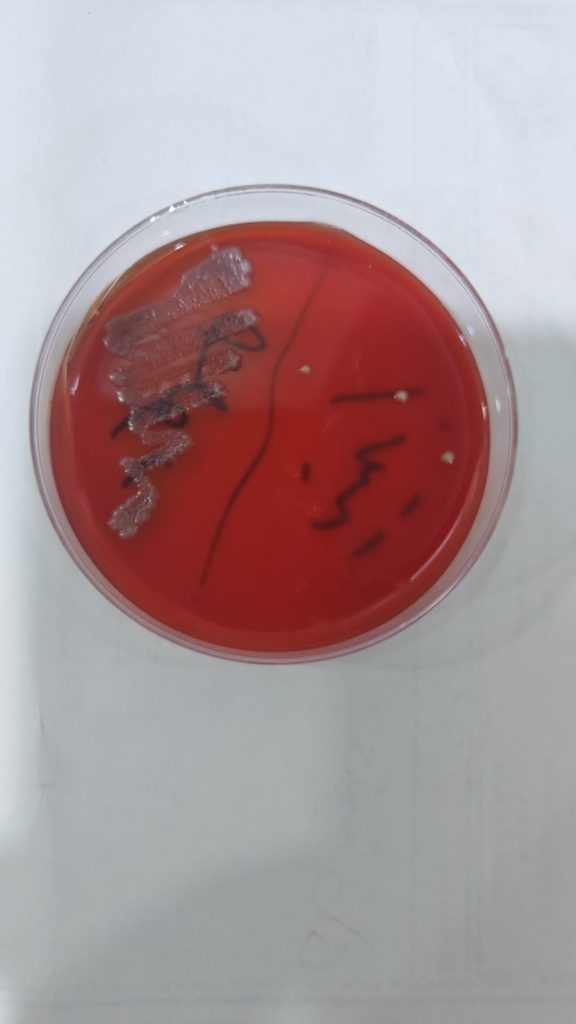

دورة في كلية العلوم بعنوان قياس الفعالية البايولوجية للمركبات الكيميائية في الأوساط الزرعية.
نظم قسم علوم الأدلة الجنائية في كلية العلوم بجامعة دورة تدريبية بعنوان: “قياس الفعالية البايولوجية للمركبات الكيميائية في الأوساط الزرعية”،ألقى الدورة كلٌّ من المدرس المساعد علي أمجد طه والمدرس المساعد صفاء شهاب أحمد، وذلك ضمن الأنشطة العلمية التي تهدف إلى تطوير مهارات الطلبة وتعزيز الجانب العملي في المختبرات.وتناولت الدورة دراسة وتقييم الفعالية البايولوجية للمواد الكيميائية العضوية باستخدام الأوساط الزرعية في المختبرات الميكروبية، حيث تم التعرف على أنواع الأوساط الزرعية وطرق تحضيرها، إلى جانب كيفية زراعة العينات المختلفة (السريرية والبيئية والغذائية)، والتقنيات المستخدمة في قياس تأثير المواد الكيميائية على نمو الكائنات الحية الدقيقة.كما شملت الدورة اختبار الحساسية الدوائية وتفسير نتائجه، مع التركيز على ربط الجانب النظري بالتطبيق العملي في مجالات الطب والصيدلة والبحث العلمي.وتضمنت محاور الدورة التطرق إلى مفهوم الفعالية البايولوجية وأهميتها في العلوم الطبية، وتمييز أنواع الأوساط الزرعية واختيار الأنسب منها، فضلاً عن تحضير الأوساط الزرعية بشكل صحيح ومعقم، وزراعة مختلف أنواع العينات بطريقة علمية دقيقة.وشهدت الدورة تدريب المشاركين على تطبيق طرق قياس الفعالية البايولوجية، مثل تقنية الانتشار بالأقراص، والتخفيف (MIC)، إضافة إلى تحليل نتائج اختبار الحساسية الدوائية وتفسيرها، وتقييم كفاءة المواد الكيميائية والمضادات الحيوية، مع التأكيد على الالتزام بإجراءات السلامة الحيوية داخل المختبر.وتأتي هذه الفعالية انسجاماً مع أهداف التنمية المستدامة، لاسيما الهدف الثالث: الصحة الجيدة والرفاه، من خلال دعم البحث العلمي في المجالات الطبية وتعزيز فهم التفاعلات الحيوية التي تسهم في تطوير العلاجات والمضادات الحيوية وتحسين الصحة العامة.